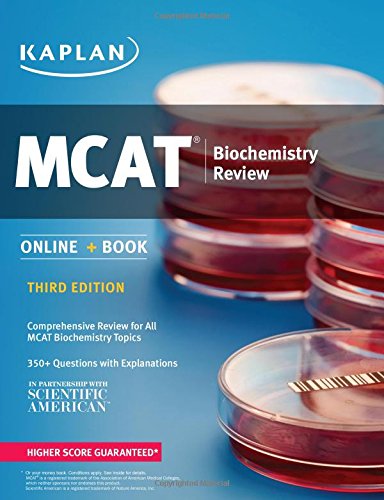

All Departments
MCAT Biochemistry Review: Online + Book (Kaplan Test Prep)
Brand: Kaplan Publishing
Last Update: 2019-09-23 02:10:34